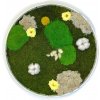
Machový obraz - Kruh paradise Veľkosť rámu: 60cm

obraz
Našli sme na Heureka.sk
|
Nájdených viac ako 1000 záznamov (zobrazujem 121 až 140)
Cena vrátane DPH
|
|||
Obraz na plátne kríž 100x50 cmV súčasnej dobe zdobenie stien je umením ako sa preraziť. Obraz na plátne kríž zavesený vo vstupnej miestnosti zapôsobí na každého návštevníka, v spálni poteší zrak majiteľa a v kancelárii sa môže stať skvelým znázornením štýlu spoločnosti. Obraz na plátne kríž je vkusným riešením súčasného interiér... |
31,95 € |
||
Obraz na plátne Cave prekročí vtáky 100x50 cmObraz na plátne Cave prekročí vtáky je v digitálnej kvalite alternatívou k starej dekorácii steny maľbami. Ide o výrobok, ktorý vďaka veľmi dobrej kvalite potlače a precíznemu prevedeniu vycibrene ozdobí každý moderný interiér. Obraz na plátne Cave prekročí vtáky na vlastnej stene je spôsobom, ako z... |
31,95 € |
||
Obraz canvas Marble kameň škvrny 100x50 cmNevšedný byt nemôže byť bez moderných doplnkov, ako je Obraz canvas Marble kameň škvrny. Dnes radi spestrujeme výzdobu miestností niečím viac než len orámovanými rodinnými fotografiami. Dekorácia stien pomocou Obraz canvas Marble kameň škvrny, to je čistá radosť, podporená digitálnou technológiou po... |
31,95 € |
||
Obraz canvas Marble kameň betón 100x50 cmKreatívny byt nemôže byť bez inovatívnych doplnkov, ako je Obraz canvas Marble kameň betón. Dnes radi spestrujeme výzdobu miestností niečím viac než len orámovanými rodinnými fotografiami. Dekorácia stien pomocou Obraz canvas Marble kameň betón, to je úplná radosť, podporená modernou technológiou po... |
31,95 € |
||
Obraz canvas horské zimné 100x50 cmObraz canvas horské zimné je v digitálnej kvalite alternatívou k starej dekorácii steny maľbami. Ide o výrobok, ktorý vďaka vysokej kvalite potlače a starostlivému prevedeniu vycibrene ozdobí každý moderný interiér. Obraz canvas horské zimné na vlastnej stene je spôsobom, ako zdokonaliť a spestriť s... |
31,95 € |
||
Obraz canvas vresy 100x50 cmObraz canvas vresy je v digitálnej kvalite alternatívou k tradičnej dekorácii steny maľbami. Ide o výrobok, ktorý vďaka veľmi dobrej kvalite potlače a starostlivému prevedeniu štýlovo ozdobí každý súčasný interiér. Obraz canvas vresy na vlastnej stene je spôsobom, ako zdokonaliť a obohatiť svoju mie... |
31,95 € |
||
Helma 365 Drevený obraz Graffiti*Výpredaj kolekcie - porovnanie s najnižšou cenou po dobu 30 dní pred prvým poskytnutím zľavy, ktorá sa postupne zvyšovala. Originálny darček pre vašich blízkych a obchodných partnerov. Individuálne obrazy (vami dodané motívy) pre vás vytlačíme od 25 kusov na drevenú preglejku, či na biely štruktúr... |
10,02 € |
||
Obraz na plátne CAN 50150 mesto 150x50 cm |
66,52 € |
||
Drevený obraz na stenu Najsvätejšie srdce Ježišovo III. (Motív v odtieni orech)Obraz v modernom, jednoduchom a elegantnom prevedení. Ak hľadáte pre svoj domov pekný náboženský motív, aleboak rozmýšľate nad darčekom pre Vašich blízkych pri rôznych príležitostiach,či je to jubileum, svadba, sviatosť birmovania, určite si z našej bohatej ponuky vyberiete.♥ pre Vás - pre Vašich bl... |
26,00 € |
||
Krajina motýľov - Katarína Haraksimová, originálny, ručne maľovany obraz L (do veľkosti 95x95cm) Viac fariebAutor: Katarína Haraksimová Názov: Krajina motýľov Technika: komb.technika Rozmer: 78x108 cm - Obraz v ráme |
510,00 € |
||
Obraz v lištách Pávová pivónia (35x45 cm) vykladanie z diamantovNádherná umelecká súprava kryštálového umenia. Každý motív má očíslovanú samolepiacu šablónu. Pomocou šikovného pera (súčasťou balenia) jednoducho zdvihnite farebný kryštál a umiestnite ho na zodpovedajúcu očíslovanú bodku na vašom projekte. Kryštál sa okamžite prilepí! Výsledkom práce je ohromujúci... |
28,79 € |
||
Machový obraz - Kruh paradise Veľkosť rámu: 60cmObraz so stabilizovaným machom, stabilizovanými rastlinami a kvetmi" je výnimočným umeleckým dielom a zároveň dekoračným prvkom, ktorý kombinuje rôzne stabilizované prírodné materiály. Stabilizovaný mach, stabilizované rastliny a kvety sú všetky materiály, ktoré prešli procesom stabilizácie, aby si ... |
200,00 € |
||
Mikroskop Bresser RESEARCHER ICD 20x-40x-80x LED (Zväčšenia 20x/40x/80x, 3D obraz, okuláre WF10x/20x, univerzálne využitie)Stereoskopický mikroskop Bresser Researcher ICD 20x-40x-80x LED je univerzálna stereolupa so zväčšeniami 20x/40x/80x určená predovšetkým na priestorové 3D pozorovanie nepriehľadných materiálov (minerály, rytiny, známky, miniatúry, elektronické obvody, PCB), ale čiastočne využiteľný aj ako biologický... |
279,00 € |
||
Obraz dřevěný: Abstract, 630x315Dřevěný obraz, rozměr: 630x315 |
12,49 € |
||
Obraz dřevěný: Graffiti, 450x520Dřevěný obraz, rozměr: 450x520 |
11,89 € |
||
Plagát, Obraz - Spiral galaxy, illustration of Milky Way, alex-mit, 40 × 30 cmPlagát Spiral galaxy, illustration of Milky Way sa hodí na každú stenu. Tlačené na kvalitný papier, ľahko zrolovateľné do tuby. Možnosť profesionálneho rámovania a laminácie. Široká ponuka plagátov – viac ako 10 000 motívov na sklade!. Rýchle dodanie a nové produkty každý týždeň. Ideálny ako darček ... |
15,99 € |
||
OKI Čierny obraz. valec do C822/831/841 (30.000 str) 44844408Černý obraz. válec do C822/831/841 (30.000 str) |
229,43 € |
||
Obraz kvety 3219J 30x40cmGobelínové plátno - stramín 4 dierky na 1cm s potlačeným obrázkom. Gobelín vyšívame gobelínovým stehom. Na požiadanie vieme poslať ku obrazu aj mulinky buď značku Česká Třebová, alebo Anchor Rozmer:30x40cm Dodanie:ihneď Cena je uvedená za 1ks Dodavateľ: Orchidea Objednávkové číslo:3219J |
13,30 € |
||
Plagát, Obraz - The Big Lebowski - Eyes, 61 × 91.5 cmPlagát The Big Lebowski - Eyes sa hodí na každú stenu. Tlačené na kvalitný papier, ľahko zrolovateľné do tuby. Možnosť profesionálneho rámovania a laminácie. Široká ponuka plagátov – viac ako 10 000 motívov na sklade!. Rýchle dodanie a nové produkty každý týždeň. Ideálny ako darček pre všetkých fanú... |
5,99 € |
||
Plagát, Obraz - Transformers: Rise Of The Beasts - Primal Rage, 61 × 91.5 cmPlagát Transformers: Rise Of The Beasts - Primal Rage sa hodí na každú stenu. Tlačené na kvalitný papier, ľahko zrolovateľné do tuby. Možnosť profesionálneho rámovania a laminácie. Široká ponuka plagátov – viac ako 10 000 motívov na sklade!. Rýchle dodanie a nové produkty každý týždeň. Ideálny ako d... |
4,49 € |
||
|
« Předchozí 1 … 5 6 7 8 9 … 50 Další » Nájdených viac ako 1000 výsledkov |
|||